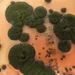
استفاده از قارچ سیاه چرنوبیل برای محافظت فضانوردان در برابر تشعشع

فهرست مطالب
پژوهش جدید نشان میدهد حافظه بلندمدت با یک کلید ساده شکل نمیگیرد، بلکه از طریق سلسلهبرنامههای ژنی و تایمرهای مولکولی در بخشهای مختلف مغز بهتدریج تثبیت میشود.
به گزارش سرویس علمی تکناک، دانشمندان علوم اعصاب سالها میدانستند مدلهای رایج مطالعه حافظه، واقعیت پیچیده تصمیمسازی مغز درباره انتخاب و ماندگاری خاطرات را به شکل افراطی ساده میکنند. اکنون پژوهشی تازه نشان میدهد شکلگیری حافظه بلندمدت حاصل «آبشاری از تایمرهای مولکولی» است که در نواحی مختلف مغز یکی پس از دیگری فعال میشوند.
دههها تمرکز مطالعات بر هیپوکامپ و قشر مغز بود؛ ساختارهایی که بهترتیب مسئول ذخیرهسازی کوتاهمدت و بلندمدت دانسته میشدند. با وجود اینکه این چارچوب به کشفیات مهمی منجر شد، اما هرگز تصویر کامل را ترسیم نکرد. پرسش کلیدی همچنان بیپاسخ مانده بود: چرا بعضی خاطرات فقط چند هفته دوام دارند، اما برخی دیگر یک عمر همراه انسان میمانند؟
پیشنهادی: حافظه مغز انسان هر شب ریست می شود
پلزدن تازه در این حوزه از سوی پریا راجاسِتوپاتی، رئیس آزمایشگاه دینامیک عصبی و شناخت اسکولر هورباخ، انجام شده است. او بر یافتههای مهم سال ۲۰۲۳ تکیه میکند؛ یافتههایی که نقش تالاموس را بهعنوان حلقه واسط بین حافظه کوتاهمدت و بلندمدت آشکار کرد.
تالاموس نهتنها خاطرات ارزشمند را انتخاب میکند، بلکه آنها را برای نگهداری طولانیمدت به قشر مغز هدایت میکند. طبق بیانیه منتشرشده، این مطالعه به پژوهشگران امکان داده لایههای پنهان و پیچیده سازوکارهای شکلگیری و تثبیت حافظه را دقیقتر بشکافند.
پرسشهای محوری این پژوهش چنیناند: «خاطرات پس از خروج از مرحله کوتاهمدت در هیپوکامپ چه سرنوشتی پیدا میکنند؟ چه نیروهای مولکولی در روند ارتقای خاطرات مهم به قشر مغز و حذف تدریجی خاطرات کماهمیت نقش دارند؟»
محققان برای پاسخ، یک مدل رفتاری مبتنی بر واقعیت مجازی طراحی کردند تا موشها خاطرات معینی بسازند. نتیجه نهایی تصویری تازه از حافظه ارائه میدهد. حافظه بلندمدت نه یک دکمه خاموش و روشن ساده، بلکه زنجیرهای دقیق از «تایمرهای مولکولی» است که در زمان مناسب فعال میشوند و خاطرات را ماندگار میکنند.
حتما بخوانید: تاثیر فلوراید آب بر سلامت مغز!

بیشتر بخوانید: ساخت اولین بافتهای مغز مصنوعی در آزمایشگاه
01
از 02خبری از کلید روشن و خاموش نیست!
راجاسِتوپاتی در بیانیه مطبوعاتی توضیح میدهد: «مدلهای کلاسیک حافظه در مغز بر پایه مولکولهایی بنا شدهاند که مانند ترانزیستور رفتار میکنند؛ ساختارهایی که یا روشناند یا خاموش.» اما پژوهش تازه، این تصویر دوحالته را به چالش میکشد.
تیم او با اتکا به پیشرفتهای اخیر، توانست مرحلهای تازه از فهم سازوکار یادآوری در مغز را بگشاید و مسئله را از زاویهای کاملا متفاوت دوباره صورتبندی کند. پژوهشگران با تغییر تعداد دفعاتی که یک تجربه برای موشها تکرار میشد، توانستند میزان ثبت خاطرات را دستکاری کنند. برخی از موشها خاطرات را پایدارتر نگه میداشتند و همین تفاوت، محققان را به جستوجوی سازوکارهای مسئول پایداری حافظه در مغز هدایت کرد.
برای مطالعه بیشتر: آیا ظرفیت حافظه مغز انسان محدود است؟
اما مشاهده همبستگی کافی نبود. در همین مرحله، سلین چن، همسرپرست تحقیق، یک پلتفرم غربالگری مبتنی بر CRISPR توسعه داد تا ژنهای تالاموس و قشر مغز را بهطور هدفمند دستکاری کند.
بر اساس توضیحات ارائهشده، این ابزار نشان داد حذف برخی مولکولها بهطور مستقیم مدتزمان زندهماندن خاطره را تغییر میدهد. مهمتر اینکه هر مولکول در مقیاس زمانی متفاوتی عمل میکرد و همین یافته بار دیگر ثابت میکند حافظه بلندمدت نه یک کلید ساده، بلکه حاصل شبکهای چندلایه از زمانسنجهای مولکولی است.
02
از 02تایمرهای مولکولی آینده مطالعات مغز را تغییر میدهند؟
نتایج پژوهش نشان میدهد حافظه بلندمدت نه یک مکانیسم ساده روشن و خاموش، بلکه حاصل هماهنگی لایهبهلایه «برنامههای تنظیمکننده ژن» است؛ فرآیندی که در گذر زمان و در سراسر مغز همچون ردیفی از زمانسنجهای مولکولی فعال میشود.
بر اساس مدل ارائهشده، پس از آنکه هسته اولیه خاطره در هیپوکامپ شکل گرفت، مولکول Camta1 و مجموعه اهداف ژنتیکیاش مسئول تضمین پایداری اولیه آن هستند. با گذشت زمان، Tc4 و اهداف آن وارد عمل میشوند و از طریق تقویت چسبندگی سلولی و حمایت ساختاری، ستونهای حافظه را محکمتر میکنند. در مرحله نهایی، Ash1l با فعالسازی برنامههای بازآرایی کروماتین، سطح ماندگاری خاطره را به مرتبهای پایدارتر ارتقا میدهد.
راجاسِتوپاتی در توضیح این یافتهها هشدار میدهد: «اگر خاطرات وارد این چرخه زمانسنجها نشوند، مغز برای فراموشکردن سریع آنها آماده خواهد بود.»
این نتایج میتواند پیامدهای مهمی برای مطالعه و درمان بیماریهای مرتبط با اختلال حافظه داشته باشد.
نسخه کامل پژوهش در نشریه Nature منتشر شده است.